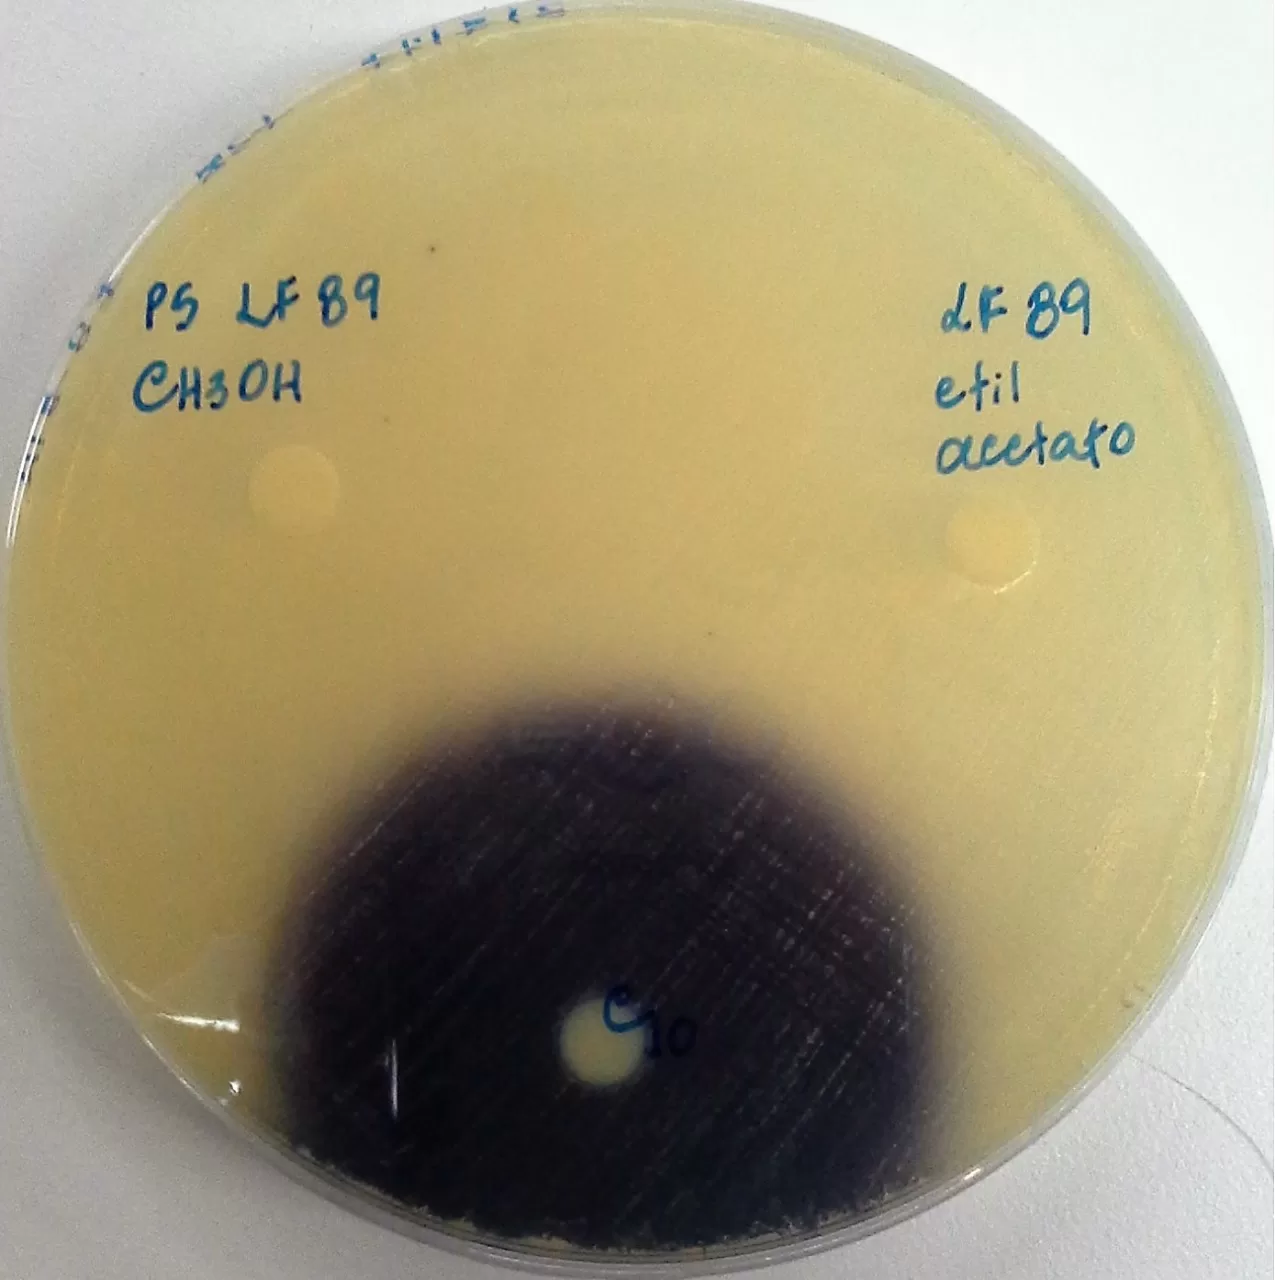

En la comunicación celular en bacterias, la utilización de moléculas señales o autoinductores, permite la regulación de ciertos procesos fisiológicos dentro de una población bacteriana, cuando se alcanza cierta densidad poblacional, denominándose comúnmente quorum sensing.
En un trabajo colaborativo titulado “Piscirickettsia salmonis does not evidence quorum sensing based on acyl‐homoserine lactones” de los autores Dr. Héctor A. Levipan (Universidad de Playa Ancha), Dr. Luis Reyes‐Garcia (Universidad Santo Tomás de Viña del Mar) y Dr. Ruben Avendaño‐Herrera (Investigador Principal del Centro INCAR y Director del Laboratorio de Patología de Organismos Acuáticos y Biotecnología en Acuicultura de la Universidad Andrés Bello), se ha logrado generar nuevos conocimiento sobre este importante patógeno (P.salmonis) de la industria salmonicultura chilena, evaluando la capacidad del patógeno de producir moléculas de comunicación tipo acilo homoserina lactona (AHL).
El estudio concluye que “ni los ensayos basados en biosensores ni la cromatografía-espectrometría de masas detectaron señales del tipo AHL en los extractos de disolventes orgánicos obtenidos de los sobrenadantes de cultivo de la cepa tipo P. salmonis LF-89T y el aislado chileno CA5. Por tanto, la presente investigación no respalda la existencia de un circuito quorum sensing basado en la generación endógena de moléculas del tipo AHL por P. salmonis”, explicaron los autores.
“La detección de mecanismos de quorum sensing basada en AHL es uno de los sistemas de señalización bacteriana más estudiados en microbiología, incluidos patógenos bacterianos clínicos, en los que el circuito de comunicación es dependiente de las proteínas de la familia LuxI / LuxR. En este contexto, P. salmonis tiene más de una copia del gen luxR, pero esta bacteria carece de ortólogos del gen luxI que codifiquen las sintasas AHL de la familia LuxI”, denotan los autores.
Sin embargo, algunas bacterias pueden generar moléculas de AHL a través de vías de síntesis alternativas, es decir, en ausencia de homólogos de LuxI. Por tanto, ante la diversidad de AHL que se están descubriendo, la comunicación entre bacterias de P. salmonis continúa siendo un tema de investigación. En este sentido, el estudio entrega el primer derrotero sobre este tópico de investigación en P. salmonis, indicando que “se necesita más investigación para establecer cualquier posible influencia de fuentes exógenas de AHL y/o homólogos estructurales de AHL sobre el comportamiento colectivo del patógeno”.
Revisa el paper a continuación:
Fotografía Placa con la cepa tipo de Piscirickettsia salmonis LF-89 con la cepa indicadora VIR07 y como control positivo C10. (Fuente: Ruben Avendaño-Herrera & Héctor Levipan)